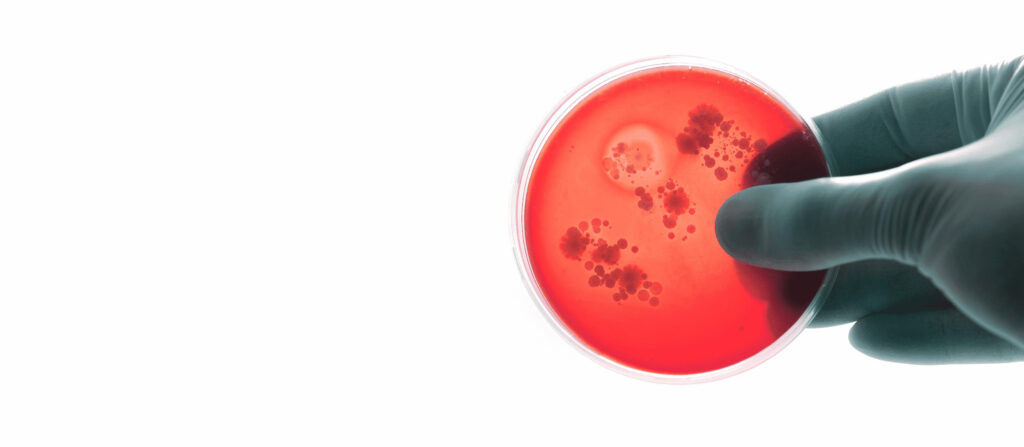

Contact us
Pioneering
clinical disease
diagnostics
The right treatment starts with the right diagnosis
We help healthcare professionals make fast, accurate decisions – and ultimately enable better treatment outcomes for patients worldwide.
SSI Diagnostica Group is a global leader in infectious disease diagnostics, uniting five portfolios – SSI Diagnostica, TECHLAB, Beijing Genesee Biotech (BGB), CTK Biotech, and Gulf Coast Scientific. We operate as one company and offer over 200 years of combined scientific expertise and a highly specialized product portfolio.
Gastrointestinal
Solutions for infectious gastrointestinal diseases
Respiratory
Innovative products and unparalleled expertise in respiratory diagnostics
Bloodborne
Portfolio solutions for tropical, parasitic and sexually transmitted diseases
General Microbiology
Microbiological testing & research solutions to meet diverse laboratory needs



